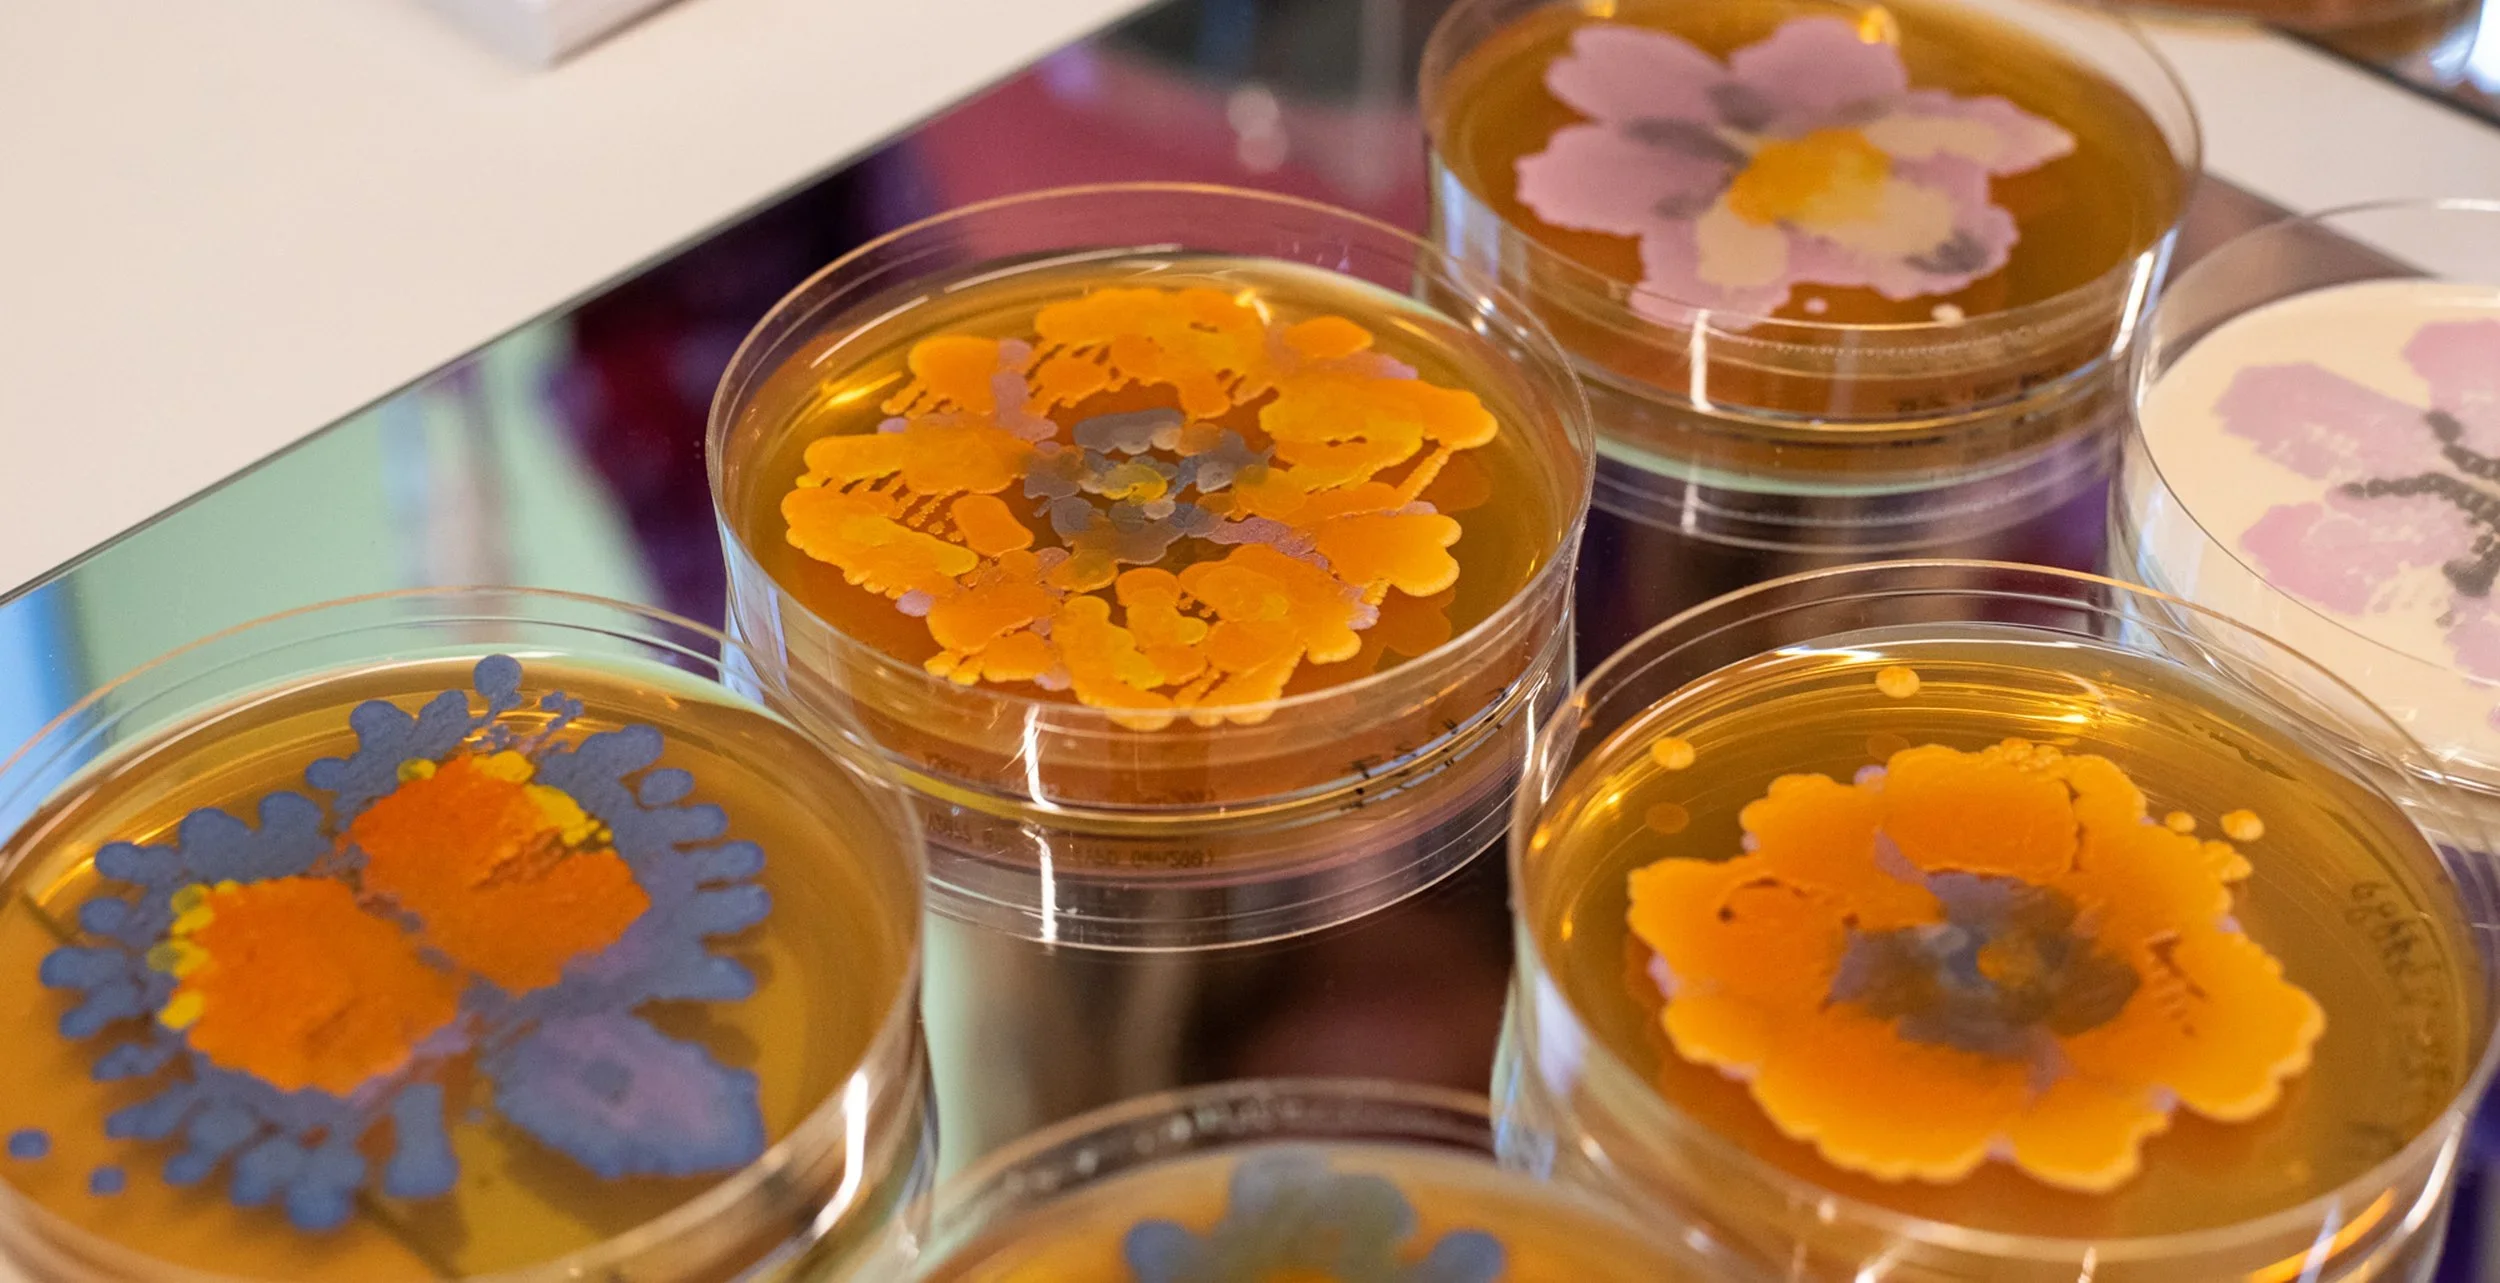
Karen Ingram

ARTIST RESIDENCIES
ONLINE + NYC
📶 REMOTE RESIDENCY
NEXT DEADLINE: JUNE 30, 2026
+ Durations of 1 or more months
+ Weekly Meetings
+ Studio Practice & Project Advising
+ Online Exhibitions
⏹️ STUDIO RESIDENCY
ROLLING DEADLINE: REVIEWED MONTHLY
+ 1-Week & 1-Month Sessions Available
+ 350 sq ft Brooklyn Studio
+ Online Exhibition
+ Optional Studio Visits & Open Studio
REMOTE ARTISTS-IN-RESIDENCE
2026
2025
Featured